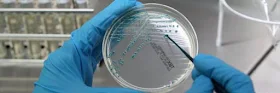

“Qua, così”… la storia continua a ripetersi, ossia “la storia si ripete”.
Ma, lo farebbe in ogni caso. Anche “qua, non così”.
Perché? Perché è insita, nella “creazione”, quella “molla” che rende tutto un “riflesso… ad immagine e somiglianza”.
Si potrebbe insistere e ritenere/percepire che, lo strumento per la creazione sia, ad un livello al di là dell’apparenza (macro, micro), proprio ciò che – per ogni aspetto inferiore o “umano, ‘qua così’” – non risulta essere percepito come tale e cioè:
- la “leva”, che permette – con “agio” – di terra riformare un intero ambiente (a prescindere dalla sua estensione).
In SPS, è emersa (accortezza) la meccanica frattale espansa, a capo di ogni “cosa”.
Qualcosa che risale ad una tecnologia infrastrutturale, che riguarda/abbraccia tutto… ma a livello di “creazione ambientale potenziale (spazio sostanza per il contenitore)”.
Ossia, un simile evento creativo è più simile ad un progetto complessivo, che prende in esame qualsiasi tipo di possibilità, sempre previsto “in potenza” e dipendente dal “come le cose si radicheranno e si svilupperanno, in forza di eventi lasciati liberi di accadere, da una ragione fondamentale che sviluppa interesse in tutto questo, a prescindere dalla forma che prenderà”.
La tecnologia non ricordata, dagli umani ivi contenuti, è quella che “probabilmente non hanno mai nemmeno conosciuto”, essendo asset nel/del “progetto”.
Umani che sono di natura ibrida e tri-unitaria, tuttavia.
Ossia, che preesistono a tutto ciò, in qualche "forma" che ora sembra solo una “fantasia (con la propria ragione sovrana, centrale o… egoica, che li ha sempre convinti a mettersi al centro, in luogo di accorgersi di ciò che ‘non esiste ma c’è’).
Questo Bollettino (nella seconda parte di una argomentazione assai sfuggevole) è incentrato sulla “creazione”. Una creazione secondaria (per parte dominante), terziaria (per parte umana, dominata) e primaria (per parte progettante l'esperimento).
Ora, le cose potrebbero essere assai più semplici, se tu riuscissi ad ammettere, in te (oltre alla selva di caos apparente, nel quale sei immerso/a “qua, così”), che – alla base di tutto – possono esserci sempre solo, porzioni/parti di umanità (scissa, divisa, separata, distaccata, isolata, illusoriamente impegnata a progettare, creare, dominare, livello per livello).
Chi, infatti, può sostenere a pieno titolo (con la verità in bocca) che “sia così o non sia così”?
Nessuno. Neanche SPS. Ma, nemmeno ogni altra presenza sulla Terra. Forse il Dominio (in quanto "backup" inconscio, di ciò che è già successo) in quanto parte coinvolta "mani e piedi" e, per intero, "ricordante".
Poiché l’argomentazione in questione (la “creazione”) appartiene ad un livello della consapevolezza, che è anche memoria ed esperienza propria, non filtrata da nulla, nel mezzo.
Ossia, dovresti essere eterno/a, al fine di non dipendere, da quello che sai “perché te lo hanno detto”.
In SPS si è sviluppata una “lente frattale espansa”.
Un tipo di logica.
Qualcosa che parte sempre dalla considerazione attuale, del reale manifesto. Dall’accorgersi di quale “forma” ha, per via di quello che succede in ogni punto del pianeta. È, dunque, una disamina sensata, che avanza e si sviluppa in seguito al modello di paradigma, “al di là degli usi e costumi locali, globalizzati – però – a livello superiore e sostanziale”.
Non è fantasia. È misurazione del reale manifesto, a partire da ciò che più lo caratterizza e “qua, così”… la caratteristica più espansa ed “evoluta” è l’ingiustizia (la "traccia frattale espansa" della gerarchia piramidale e del controllo. Anche se non manifesta, la causa c'è e lo percepisci anche così).
Ok?
È difficile credere il contrario, se non affidandosi ai moti religiosi (e persino spirituali), che fungono da agenti dopanti, al fine di “sopportare in vita, per meritarsi qualcosa di indefinito e di virtuale, dopo la vita stessa”. Ossia:
- rimandando a "domani", quello che puoi fare "oggi/ora".
All’interno dello status quo, il firewall ambientale è sempre di natura dominante, ossia, tende a sviluppare “eventi” in funziona strategico difensiva, pro Dominio (AntiSistema).
Avendo chiara una certa panoramica “superiore (ragione fondamentale)”, SPS si è accorto che tutto il resto diviene conseguenza, e – quindi – che tutto ciò che tu indaghi e prendi come “causa”, è ad ogni effetto “già conseguenza”.
Omettendo dall’equazione, la compresenza non manifesta del Dominio, tu scali tutto di una ottava, e in un insieme frattale espanso “va ancora bene (perché si replica sempre anche la ragione fondamentale”, ma… se non ti accorgi (non hai memoria, lato tuo) della ragione fondamentale, allora anche nella frattalità espansa, che caratterizza tutto, ti puoi sempre disperdere e diluire (disinnesco).
![]() |
| Il "Dio... genetico", in leva ("causa seconda" o Dominio)... |
Merita sottolineare che in alcuni maestri dell’arte moderna scompare Dio nella raffigurazione della creazione. Così, ad esempio, in Maurits Cornelis Escher…Escher, pur riferendosi a Genesi, rappresenta non la creazione, bensì solo le opere create o, si potrebbe dire, la natura.Il fatto che Dio non crei “direttamente”, bensì attraverso le “cause seconde” è rappresentato nell’iconografia medioevale attraverso l’immagine del Creatore che crea utilizzando un compasso:
l’uomo ha quindi il dovere di indagare le leggi interne del creato...Link
L’uomo ha quindi il dovere di indagare le leggi interne del creato (l'umano è, quindi, un... contenuto, che non si accorge di essere tale).
Le “cause seconde” hanno più “orientamenti alla lettura”:
- per delegazione frattale espansa, il Dominio crea per “cause seconde (in leva, indirette, circuito secondario)”
- senza accorgerti, crei per “cause seconde”, ossia… “in ragione inconscia della dominante”
- ce ne sono molte altre, ovviamente, perché l’infrastruttura reale manifesta, poggia su "basi, colonnato, tetto" ed ogni parte “serve”, auto replicandosi in loco “ad immagine e somiglianza” della ragione fondamentale o “grande concentrazione di massa”.
Tutto “qua, così” ha natura militare (segno di una "evoluzione sulla difensiva". Chi/cosa teme, ha paura, si nasconde, si cela, si... rivela?).
Proprio ciò che... domina (l'agente virale non manifesto).
Infatti, le “innovazioni tecnologiche e non solo”… si progettano, sviluppano e sperimentano proprio nel campo della “guerra o della difesa della pace”. È la “prevenzione”. La “sicurezza” dei propri confini, per garantire il proprio “stile di vita” alla popolazione radunata e contenuta, regno per regno, stato per stato, etc.
![]() |
| Il DominIO agisce su/in qualcosa che già esiste... |
Dio è rappresentato come un “creatore secondario”, in alcune opere ed in alcuni ambiti “artistici”. Perché?
Perché configura e rappresenta il Dominio, non la dominante né tantomeno la ragione infrastrutturale/potenziale, che permette la costruzione di qualsiasi tipo di reale manifesto (come avendo a disposizione una scatola infinita di Lego, potendoci fare quello che si vuole. L’importante è usarli, generando qualcosa d’insieme, che è l’utilizzo, il consumo, il “lavoro”, l'esperimento, l'evocazione, etc.).
Al di là di “tutto ciò che pensi, immagini o non pensi, non immagini”… c’è un “disegno (comunque esistente)”. Qualcosa che “è” e che – “ora, ‘qua così’” – ti è precluso anche solo avvicinare con la fantasia più sfrenata.
E non è detto che... non sia ancora “umano”.
L’umanità è, però, di più… qualcosa come una sorta di “travestimento”:
- tu non sei il “tuo” corpo
- tu sei qualcosa che “lo abita”
- chi/che cosa sei?
Sei l’immagine frattale espansa, riflessa, di “qualcosa che si nasconde, che pilota, che fa esperienza, che monitora, controlla, è… prigioniera, etc.”.
Tutto questo ed altro, insieme ed allo stesso tempo.
Ossia? Un esperimento.
Come lo puoi comprendere? Osservando frattalmente i segni frattali espansi. Qualcosa che... “devi lasciare da parte ogni credo, fede, teoria, speranza, paura, etc.”.
Ecco la riprova frattale espansa (se non ti basta, sei davvero la conferma della tesi SPS: sei un organismo artificiale, geneticamente modificato, ossia, sempre… lo stesso esperimento, al quale non credi).
![]() |
| "Albero della Vita"... |
Vita artificiale: creato primo batterio sintetico.Creato il primo batterio sintetico capace di generare la vita artificiale.
La scoperta, il cui annuncio è stato dato dalla rivista Science, è degli scienziati Usa Craig Venter e Clyde Hutchison che hanno sintetizzato nel loro laboratorio in California un genoma batterico minimo, composto da 473 geni e contenente i geni necessari per la vita.
LinkNel 2005 il team di scienziati era già riuscito a realizzare un batterio artificiale, ma stavolta viene messo insieme il genoma minimo essenziale a supportare la vita.
“Creato il primo batterio sintetico capace di generare la vita artificiale…”. Ok?
Da “ora” hai una idea precisa di “cosa è la vita”:
- cosa è? Creazione artificiale, di parte (sulla base del già esistente).
Se risali la corrente frattale espansa, “dove/a cosa”… arrivi?
Alla “tua” origine fondamentale (alla "programmazione"):
- a “Dio”
- al Dominio
- alla dominante
- all’esperimento (potenziale di creazione “libera”).
In tutto ciò, c’è la possibilità che “tu sei qualcosa di diverso, persino dall’esperimento”. Te ne accorgi?
Ma, avanzando in una simile modalità, a cosa giungi? Ancora ad una forma di te, non libera, ossia… ingabbiata in un esperimento.
È ancora la mente attuale, a governare tutto ciò?
A livello frattale espanso, è centrale quello che ti succede “ora, ‘qua, così’”.
È da "questo" che parti e derivi. Ok?
SPS si ripromette di sviluppare meglio, più linearmente, la lente frattale espansa, costituita da:
- metodo indiretto
- doppio specchio
- analogia frattale (espansa)
- il tutto “lato tuo, con te centrale al tuo centro sovrano”.
È, semplicemente, “ciò che ti riaccade ora, ad insegnarti tutto”.
Questo presente è sempre il biglietto da visita di qualsiasi “forza” presente e/o compresente.
In ogni “momento” è contenuto “tutto”…
A te, tocca la decodifica.
Capisci che è qualcosa di “immenso” da portare a termine, senza un orientamento “tuo”? Per questo, la dominante impera senza necessità di essere presente. Per questo, il Dominio impera indirettamente, pur essendo fisico quanto/come te.
E la ragione fondamentale è che “l’esperimento” è, appunto, indiretto, inondando tutto di un simile “riflesso frattale espanso”.
Perché succede? Perché lo “strumento ad hoc” progettato per un simile “creare potenziale”… è la legge, strumento, memoria, frattale espansa (una "App"):
- la funzione “leva”, che permette di governare il reale manifesto (punta di diamante dell’esperimento, in quanto sede fisica della risultanza) a partire dalla delegazione dell’intento verso l’azione stessa, in maniera non locale, indiretta, ubiqua, wireless, per “apparenti cause seconde”.
La memoria frattale espansa è un “registro”, che indica come esistente l’esperimento (i “dati” sono il cuore di ogni esperimento).
La legge frattale espansa è la “programmazione”, che sorregge il funzionamento in toto, del reale manifesto su base potenziale.
Lo strumento frattale espanso è il “braccio operativo”, che permette lo svincolarsi da qualsiasi sede/destino, in maniera tale da permettere – in teoria/nel potenziale – qualsiasi accadimento di sorta "non importa come".
Una tri-unità funzionale all’esperimento.
Creando artificialmente la vita (è ufficiale)… dov’è “Dio”?
È nella “equipe” che ha portato a termine il lavoro?
Sì, così come era in coloro che hanno partecipato alle Crociate, per andare a derubare quei popoli che avevano già un loro "Dio".
"La storia si ripete" a qualsiasi latitudine del paradigma globale e globalizzante.
Agostino dice nelle Enarrationes in Psalmos:
“Sia libro per te la pagina divina, affinché tu ascolti queste cose. Che sia libro per te il mondo intero, affinché tutte queste cose tu veda. In questi codici (cioè nel mondo) leggono tali cose solo coloro che conoscono le lettere. In tutto il mondo legge anche lo stolto”.
La Scrittura è più difficile da leggere, non tutti possono leggerla, il mondo è davanti a tutti quanti, agli occhi di tutti…Link
“In tutto il mondo legge anche lo stolto…” perché di natura frattale espansa.
Si vuole dare rilevanza a quelle che poi saranno chiamate le cause seconde, cioè le cause che sono qui, nel mondo, e che sono all’origine della generazione.
Pensate ad esempio come nessuno di noi è plasmato direttamente da Dio ma nasce da genitori.
Quindi c’è questo elemento.
Parlare di una evoluzione... lo possiamo fare soltanto come suggestione, diciamo, e volendo a livello artistico, no?
Ma assolutamente è lontano dalla mente di questi autori quella che può essere l’idea di un evoluzionismo. Anche perché quello che vi ho detto riguarda fondamentalmente la generazione del mondo.
L’idea è questa, che nell’ornatus mundi si formano, lo abbiamo visto anche nel piccolo dipinto del manoscritto, gli uccelli dell’aria, i pesci dell’acqua, e chiaramente l’autore dipinge i pesci e gli uccelli come li vede.
Quindi non c’è un’idea, diremmo noi per dirla alla maniera antica, di una successione di forme, che invece in qualche maniera potrebbe più andare verso la direzione di un’evoluzione.
Quelli che si generano al momento dell’ornato del mondo, cioè dopo la prima creazione, sono già gli animali come noi li conosciamo e già l’uomo come noi lo conosciamo.Link
Ciò che viene descritto come “ornato mondo” è, in realtà, l’infrastruttura su cui poggia il reale manifesto:
- la tecnologia a frattalità espansa, messa a punto per governare e permettere il funzionamento di realtà manifeste/potenziali, da credersi “libere”, così che spontaneamente gli attori umani possano credere di essere dotati di “libero arbitrio”.
L’esperimento sembra proiettato in una modalità “evocativa di qualcosa di contaminante”…
Qualcosa che “solo vivendo, in una atmosfera controllata all’origine”, può, nel tempo, manifestarsi.
Qualcosa che ricorda molto da vicino… la dominante (ossia, il principio di viralità, senza fisicità, in grado di possedere qualsiasi umano, e tale da trasformare – via via – chiunque in Dominio. Così che la dominante possa trasmettersi in eterno, senza mai emergere direttamente all’attenzione della Massa).
L’intuizione SPS è, dunque, quella relativa ad “umani che simulano, il più veramente possibile, la vita ‘ad immagine e somiglianza’ di se stessi, al fine di evocare, manifestare e eliminare… un aspetto virale, trasversale, che si propaga attraverso gli umani stessi ed i 'loro' incubi ad occhi aperti”.
L’Oltre Orizzonte riserva sorprese. Vero? Senza il Filtro di Semplificazione, ti espandi a dismisura.
Il che non sempre va bene, non sempre va nella tua direzione.
Oggi era opportuno farlo, poiché la notizia della creazione della vita artificiale, era “un rigore a porta vuota” dalla prospettiva di SPS:
- costoro non si rendono conto
che
- con una lente frattale espansa attiva
- centralmente lato proprio
- queste notizie costituiscono la “prova” di ciò che si sente/vede/percepisce
- essendo, a maggior ragione, il mondo “un libro sempre aperto”.
Osserva come “’qua, così’ tu sia considerabile… un "primitivo".
In antropologia si suole fare una netta distinzione tra il concetto di "Causa prima", identificata con il Dio-Necessità (panteismo) o col Dio-Volontà (monoteismo), e le cause "seconde", quelle fisiche, verificabili empiricamente nelle loro concatenazioni spazio temporali.
Nelle società arcaiche il concetto di causa seconda non esiste, poiché la causazione è considerata sempre come divina o comunque sacrale.Il problema è stato studiato sin dal 1922 da Lucien Lévy-Bruhl, che in "La mentalità primitiva" identificava come mistica e pre-logica la mentalità dei primitivi scrivendo:"Si vede ora la ragione profonda che rende la mentalità primitiva indifferente alla ricerca delle cause seconde.
È abituata a un tipo di causalità che nasconde, per così dire, il concatenamento di queste cause.
Mentre queste costituiscono nessi e complessi che si svolgono nel tempo e nello spazio, le cause mistiche verso le quali si rivolge quasi sempre la mentalità primitiva, essendo extraspaziali e anche talvolta extratemporali, escludono l’idea stessa di questi nessi e di questi complessi. La loro azione non può esser che immediata"...
Il pensiero primitivo, sostiene infatti Lévy-Bruhl, si svolge in forma di partecipazione agli esseri circostanti e a tutta la natura, ma è impermeabile all'esperienza, perché attribuisce lo svolgersi degli eventi a forze soprannaturali:
ecco perché il primitivo manca di logica (quale la intende l'uomo civile); ignora i principi di identità, di contraddizione e di causalità…
Link
L’indifferenza alle "cause seconde" è, per certi versi, ottimale:
perché va dritta al sodo, che non è Dio, bensì è l’accorgersi della causa prima e della ragione fondamentale (il “disegnino” che ti fanno, relativamente, ai primitivi, agli "antichi"… è estremamente riduttivo rispetto alla loro autentica portata, ora andata dispersa nella simbologia, che non puoi più capire).
Nell’analisi dello studioso, di turno, la risultanza è che – da una prospettiva frattale espansa “lato SPS” – tu sei ancora quel “primitivo”, ma senza tutto ciò che rendeva originariamente il primitivo, come “migliore di te, rispetto a come sei ora”.
A questa lettura simbolica della natura ad un certo punto si accosta un’altra lettura, una lettura che cerca in qualche maniera e vede il mondo (per dirla con l’autore che io studio, Guglielmo di Conches) come un ordinato insieme, un’ordinata collezione di creature.
Dire che il mondo è un ordinato insieme di creature vuol dire che questo ordine può essere letto, interpretato, anche con gli strumenti non tradizionali.
Questo tipo di lettura (ve lo dico subito perché credo che sia una cosa importante) non si pone subito in opposizione a quell’altra lettura, quella simbolica. Nel Medioevo spesso coesistono queste cose, più di qualche commentatore dice che si accosta e qualche volta sostituisce la lettura simbolica…
Link
Il mondo è un ordinato insieme di creature vuol dire che questo ordine può essere letto, interpretato, anche con gli strumenti non tradizionali (legge, strumento, memoria, frattale espansa, lente frattale espansa “lato tuo, centrale”, etc.).
Un ordinato insieme di creature:
- ce n’è per “tutti i gusti”, alias, per ogni “esigenza”.
La vita artificiale è realtà: realizzato il primo batterio sintetico.La vita artificiale? Potrebbe essere molto vicina. In un articolo apparso sulla rivista “Science” si descrive infatti la realizzazione di un primo batterio sintetico, dotato di un Dna minimale ma sufficiente alla sua sopravvivenza.Questo microscopico Frankenstein è creatura del team guidato da Craig Venter, pioniere della scienza che dal 1995 porta avanti i suoi studi con l’obbiettivo di ricostruire in laboratorio la vita.
La cellula prodotta è stata battezzata col nome di Syn 3.0, ed è strutturata da solo 473 geni, ognuno dei quali svolge una funzione fondamentale per tenerla in vita.Il batterio, dotato di questo minimo indispensabile alla vita, è stato realizzato nell’istituto fondato dallo stesso Craig Venter, che dello scienziato riprende anche il nome:
“Craig Venter Institute”.
I ricercatori hanno però lavorato all’esperimento diretti da Clyde Hutchinson. L’idea dalla quale sono partiti è che il genoma è analogo a un software contenente le informazioni basilari per la vita.Il traguardo giunge come esito di oltre 20 anni di ricerche, e permetterà probabilmente anche di comprendere più a fondo i meccanismi basilari della vita, con un dettaglio molto maggiore.
Il sogno di Venter è d’altro canto quello di riuscire a produrre artificialmente organismi viventi complessi, utili all’uomo. Un esempio su tutti, speciali batteri in grado di bonificare terreni o acque.Link
- l’idea dalla quale sono partiti è che il genoma è analogo a un software contenente le informazioni basilari per la vita
- comprendere più a fondo i meccanismi basilari della vita, con un dettaglio molto maggiore
- il sogno di… è d’altro canto quello di riuscire a produrre artificialmente organismi viventi complessi, utili all’uomo (certamente).
La cosa che non deve assolutamente sfuggirti è questa:
- la vita artificiale è possibile
- non abituarti anche a questo
- perché… tu non sei di origine diversa.
Ok?
Dov’è Dio... per quel “batterio artificiale”?
È in un laboratorio e si chiama “xyz”.
Quale coscienza ha di sé? Cosa “pensa”?
Sai, è solo questione di tempo.
Stai, infatti, certo/a che… con miliardi di batteri programmati ad hoc, secondo l’intenzione “divina da laboratorio, militare/commerciale”… prima o poi verrà realizzato anche “un corpo completo”.
Faranno tutto non apparentemente i batteri…
Non si tratta più di “robot”. Si tratta di vita artificiale organica.
Di cosa si nutre questo batterio?
Come si alimenta?
Quali funzioni potrebbe incarnare, nei moduli più complessi del potenziale?
“Qua, così”? Lo puoi anche solo intuire e non ti puoi sbagliare.Tutto è possibile.
"Il mondo è un ordinato insieme di creature...".
L’occhio di un insetto in una telecamera.Una telecamera digitale con un obiettivo semisferico per vedere come un insetto. Una nuova prospettiva per osservare il mondo…Link
Zanzara drone spia Usa- Pericolo privacy a livello Mondiale.Ha l’aspetto di una normalissima zanzara ma non è un essere vivente.È il nuovo prototipo Nasa richiesto dall’intelligence americana.
Dopo circa due anni di sperimentazioni, prevalentemente condotte per ridurre al minimo il pacco batterie, garantendone comunque un’autonomia notevole, la zanzara drone Usa è pronta.A quanto si apprende da un comunicato ufficiale della Cia, l’incredibile insetto artificiale verrà impiegato solo per scopi umanitari, operazioni di salvataggio e mai per spionaggio…
Tutto ciò è davvero preoccupante, ma si chiama progresso...Link
Mappato il cervello di un’ape per migliorare i droni.Mappare il cervello di un insetto sarebbe un traguardo eccezionale perché permetterebbe di usare i droni, ad esempio, a scopo agricolo.Un team di ricercatori dell’università di Sheffield e Sussex ha mappato il cervello di un’ape al fine di migliorare il funzionamento autonomo dei droni.
Nello specifico, si tratta di un’ape europea, nota come Apis mellifera, il cui cervello viene considerato “un miracolo di ingegneria” dal prof. James Marshal.
Questo drone ha funzionalità limitata in quanto emulare completamente l’attività cerebrale di un insetto lungi dall’essere finalizzata, ma si tratta di un passo nella giusta direzione.I droni sono la moda del momento…LinkUn giorno potremmo avere bisogno di questi droni per impollinare i campi.
RoboBee, sviluppati gli insetti elettronici.Hanno una massa di 80 milligrammi, un'apertura alare di 3 centimetri e battono le ali a una frequenza di 120 Hertz. Non sono colibrì, bensì sono dei dispositivi elettronici sviluppati dall'Università di Harvard che hanno le sembianze di insetti e che, come tali, sono in grado di volare…A che cosa serviranno?
Le applicazioni per i micro robot sono potenzialmente vastissime.
Sperando che non vengano usati per spiare le abitudini delle persone, possono trovare applicazione in ambito di monitoraggio ambientale, nelle operazioni di salvataggio (immaginiamo una serie di sensori che possano scovare sopravvissuti sotto una valanga di neve o tra le macerie di un edificio).Ma ancor più significativi sono i materiali e le tecniche che sono stati usati per la loro realizzazione.
"Per esempio, il processo di produzione potrebbe dare il via a una nuova generazione di dispositivi medicali complessi".
È già in programma, in effetti, la commercializzazione di alcune di queste tecnologie.In futuro il processo di produzione sarà implementato. Sarà possibile costruire macchine volanti più piccole ed efficienti con costi unitari inferiori.
La fantascienza diventa sempre più realtà…Link
Le ultime stranezze del web: robot origami e drone subacqueo.Sembra un foglio di carta uscito dalla stampante, si piega e prende forma come una farfalla, alla fine è un transformer in grado di andarsene sulle sue gambe.
L'oggetto anfibio invece si immerge, fila via con l'agilità di un pesce e trasmette immagini sottomarine, pilotabile anche con lo smartphone…Link
Combat colibrì, la nuova generazione di droni.Gli ingegneri Usa sono impegnati nello sviluppo di uccelli robot potenti e dalle dimensioni ridotte. Per volare – e spiare – indisturbati in territorio nemico…Ovviamente queste macchine hanno bisogno di un pilota che le controlli remotamente e di un team di esperti che sia in grado di analizzare con cognizione di causa le informazioni che tali apparecchi inviano al centro di controllo, ma senza dubbio, costituiscono la nuova frontiera della guerra tecnologica...
Link
La storia si ripete? A partire da… “quando/dove”?
Un essere non evoluto, l'Homo Sapiens presente sulla terra venne da loro geneticamente modificato (ingegneria genetica con aggiunta di geni Anunnaki al Dna di esseri umani preistorici), creando così un'altra specie con sembianze umane, come dice la Bibbia "a loro immagine e somiglianza", da utilizzare per i loro scopi operativi.
La teoria dell'anello mancante.
Tutto questo, secondo Sitchin, avvenne circa 150mila anni or sono e questo risponderebbe secondo lui ad una delle domande più difficili e complesse per chi studia la nascita dell'uomo, ovvero c'è un anello mancante tra l'evoluzione dell'uomo primitivo e un improvvisa ed inspiegabile accelerazione evolutiva che ha portato a quello che è definito Homo Sapiens Sapiens, il quale appare improvvisamente e nel giro di pochissimi anni (invece di milioni di anni come dovrebbe essere nel campo evolutivo), estremamente evoluto, raddoppiato di volume nel proprio cranio e nel cervello in esso contenuto, attraverso raggruppamenti sociali definiti, inizia a comunicare (quindi parlare) per comprendere meglio la divisione di ruoli da ricoprire e faccende da svolgere in comunità…
Link
Ovvero c'è un anello mancante tra l'evoluzione dell'uomo primitivo e un improvvisa ed inspiegabile accelerazione evolutiva che ha portato a quello che è definito Homo Sapiens Sapiens, il quale appare improvvisamente e nel giro di pochissimi anni...
“La natura non fa salti…”.
Charles Darwin
Darwin, pur “prendendo lucciole per lanterne”, aveva ragione:
- infatti, l’anello mancante è una frottola AntiSistemica
- e per questo, non esiste
- la natura avrebbe bisogno di molto più tempo
- per cui, non è natura ma artificio (deviazione).
La “creazione genetica funzionale” ha permesso la generazione “Big Bang” dell’umano attuale, che è sempre stato “attuale”.
“Se Dio non esiste… ogni cosa è ammissibile…”.
Dostojiewsky
E così “è”, anche se “non ti pare”.
Cos’è la vita? Chiedilo in… laboratorio.
“Lì” lo sanno.
E per la verità, indossando una lente frattale espansa “lato tuo”, lo sai anche tu. Fatichi, semmai, “solo” a crederci.
Infatti, “non credi ai tuoi occhi”…
Per "fortuna"... “la storia si ripete”, così... prima o poi, forse, ti accorgerai.
Davide Nebuloni
SacroProfanoSacro 2016/Prospettivavita@gmail.com
Bollettino SPS numero 1786

Che differenza c'e' tra generare un drone intelligente o amare una donna e "avere" un figlio da amare e proteggere fino all'eta' adulta? Ritornando a quella Conferenza "esoterica" cui ho partecipato la tesi era questa: siamo ad immagine di qualcuno, e' vero, ma nel senso di generati come si potrebbe generare un figlio.
RispondiEliminaIo credo ad un passato molto lungo "quasi eterno" in cui prima per caso e morfismo naturale, al di la' del quale ci posssiamo ancora collocare Dio, la vita intelligente e' stata generata casualmente per poi accelerare in "disegni" intelligenti con una esplosione di "singolarita'" complessa, multiforme e in competizione. Nelle nostre vite c'e' il riflesso di questi scontri titanici "celesti".
Ciao Spartan, bene. Ognuno è "libero" di credere a quello che meglio lo fa sentire.
EliminaNel mio caso, però, non è che "sto bene" ad immaginare il Dominio. Tuttavia "è uno sporco lavoro, ma qualcuno lo deve pur fare".
Grazie. Un abbraccio. Serenità...